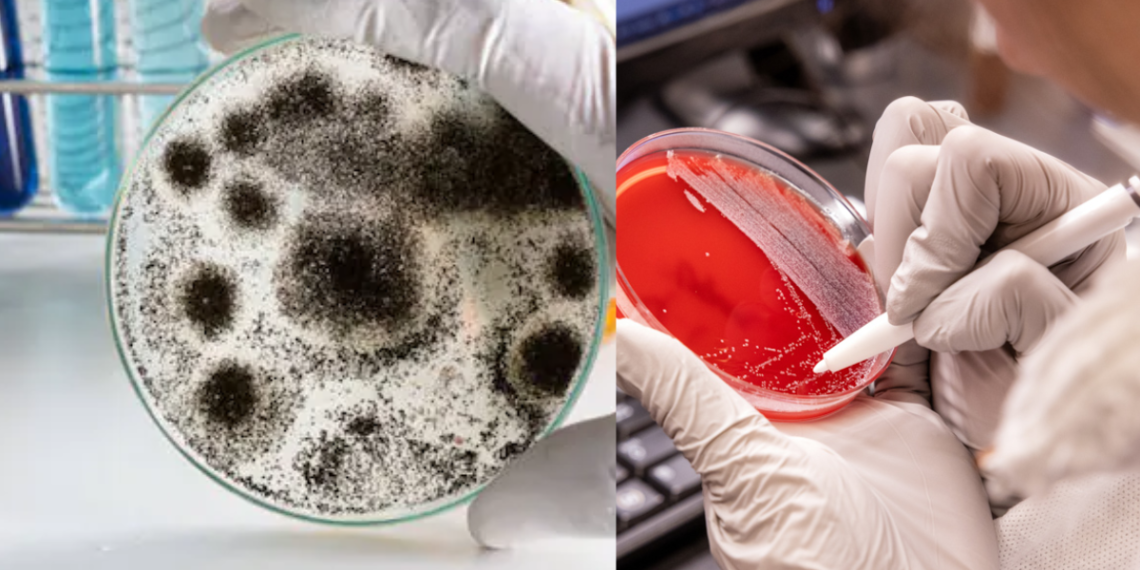
A Fungi That Can Eat Humans? Sparking A New Pandemic!

In the ever-evolving landscape of infectious diseases, one silent but deadly threat is steadily rising: Aspergillus. This genus of fungi, commonly found in soil, decaying vegetation, and indoor environments, is no stranger to the medical world. Yet, recent research and mounting cases suggest it may pose a greater threat than once imagined potentially capable of causing a widespread health crisis.
What is Aspergillus?

Aspergillus encompasses more than 300 known species of mold, with Aspergillus fumigatus being the most notorious. Most species are harmless to healthy individuals, but for those with weakened immune systems, such as cancer patients, organ transplant recipients, or people with chronic lung conditions, the consequences can be devastating.
Once inhaled, Aspergillus spores can embed themselves deep in the lungs. In healthy individuals, the immune system usually clears them without issue. But in vulnerable populations, these spores can germinate, spread, and wreak havoc literally eating the body from the inside out.
Invasive Aspergillosis: A Deadly Disease

One of the most severe manifestations is invasive aspergillosis, a fast-spreading fungal infection that attacks the lungs and can disseminate to other organs, including the brain, heart, and kidneys. The mortality rate is high up to 90% in some cases especially when diagnosis and treatment are delayed.
Unlike bacteria, fungi are eukaryotic organisms, meaning they share more cellular similarities with humans. This makes developing effective antifungal drugs incredibly challenging, as treatments that kill fungi often harm human cells too.
A Growing Resistance Problem
Adding to the danger is the growing problem of antifungal resistance. Overuse of agricultural fungicides and the limited arsenal of antifungal drugs have allowed resistant strains of Aspergillus to emerge. These so-called “super fungi” are harder to treat and may render existing medications ineffective.
Recent reports from global health organizations warn that resistant Aspergillus infections are on the rise, particularly in hospital settings where immunocompromised patients are already at high risk.
Could Aspergillus Spark a Pandemic?
While Aspergillus is not as contagious as viral pathogens like influenza or SARS-CoV-2, its potential to spark a fungal epidemic or even a pandemic is real, particularly in a world with growing numbers of immunocompromised individuals due to aging populations, cancer treatments, HIV, and organ transplants.
The COVID-19 pandemic even highlighted this threat. Many critically ill patients developed secondary infections, including COVID-19-associated pulmonary aspergillosis (CAPA), further complicating recovery and increasing mortality.
Climate change may also play a role. Warmer temperatures and altered ecosystems could increase fungal spore proliferation and human exposure, further tipping the scales.
Also Read: Realme GT 7: Delivers Smart AI Features, Massive Battery and Keeps It Budget-Friendly
What Can Be Done?
To prevent a fungal crisis, several measures must be taken:
Surveillance and Reporting: Improved tracking of fungal infections to understand their spread and resistance patterns.
Research and Development: Investment in new antifungal drugs, rapid diagnostics, and vaccines.
Hospital Protocols: Enhanced infection control practices in healthcare settings to protect vulnerable patients.
Public Awareness: Educating healthcare professionals and the public about the risks and symptoms of fungal infections.
While Aspergillus may not be the household name that viruses like Ebola or COVID-19 are, its capacity to kill from within and its potential to exploit the cracks in our healthcare defenses should not be underestimated. It represents a silent, creeping threat that could become a major public health issue if left unchecked.
The time to act is now before this fungus has the chance to unleash its full potential on a global scale.